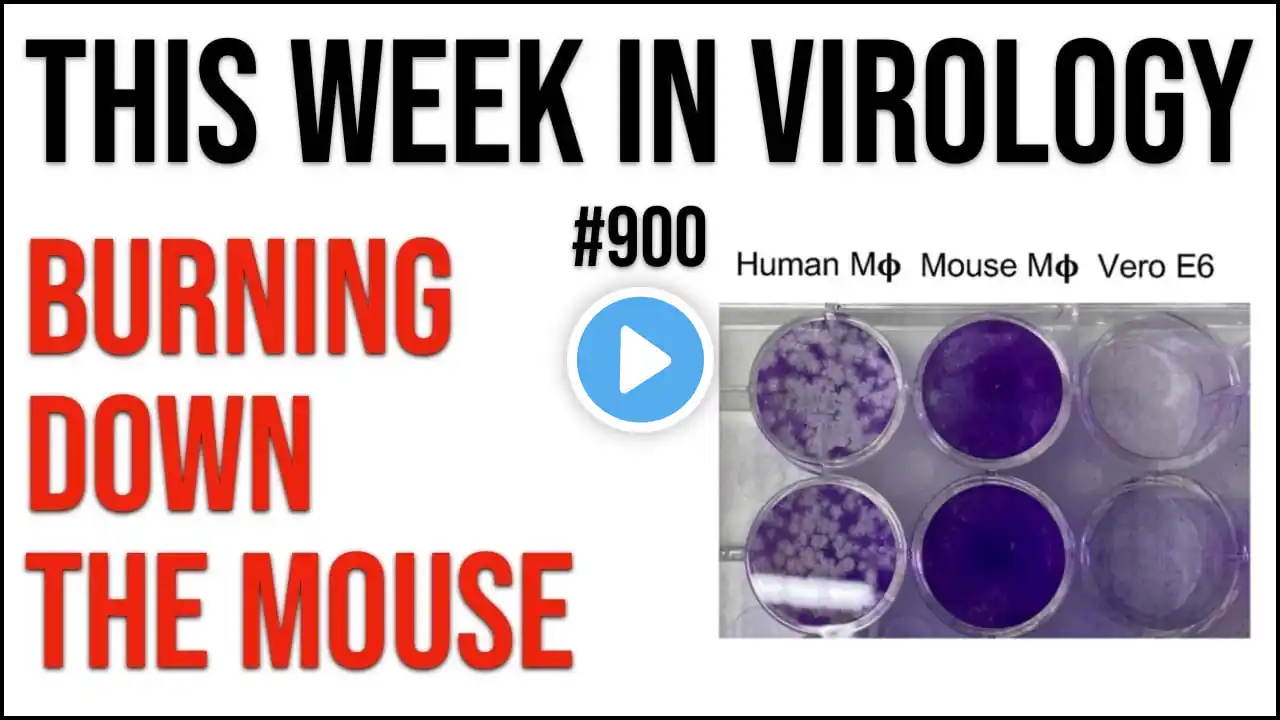
ภาพตัวอย่างวิดีโอ

TWiV 969: Carl Zimmer on COVID-19
Carl Zimmer visits the Incubator to record a wide-ranging conversation about COVID-19, including origins, vaccines, public health responses, and impact on society. Show notes at https://www.microbe.tv/twiv/twiv-969/ Become a patron of TWiV at microbe.tv/contribute ——————————— CONNECT ——————————— 🎯 Subscribe! https://bit.ly/2HOYdNP Instagram: @profvrr and @microbe.tv Twitter: @profvrr TikTok: / microbe.tv Facebook: / thisweekinvirology Our Podcasts: https://microbe.tv Contribute: https://www.microbe.tv/contribute/ ——————————— MORE VIROLOGY ——————————— •My Virology Course https://virology.ws/course •Virology Blog: https://www.virology.ws •Virus Watch https://bit.ly/3ngvQIM •Principles of Virology textbook https://amzn.to/34onDtg ——————————— OUR SCIENCE PODCASTS ——————————— •This Week in Virology https://bit.ly/30uUhrX This Week in Parasitism https://bit.ly/3ndUNUZ •This Week in Microbiology https://bit.ly/33tOUeO •Urban Agriculture http://microbe.tv/urbanag •This Week in Evolution https://bit.ly/3ne1bf5 •Immune https://bit.ly/2HOyCVb •This Week in Neuroscience https://bit.ly/2So12Yd •Infectious Disease Puscast https://bit.ly/3K4EKF0 – Who Am I? – I’m Vincent Racaniello, Earth’s Virology Professor. I’m also a professor of virology at Columbia University in New York. I’ve been doing research on viruses since 1976, and teaching virology in classrooms and online since 1999. On this YouTube channel I share videos of my lectures, podcasts, and more. New videos are uploaded several times each week. I do not run ads on our work as it is disruptive to learning. We depend on your support. If you would like to support our work, go over to https://www.microbe.tv/contribute/ ——————————————————————— #microbe #viruses #coronavirus #pandemic ———————————————————————